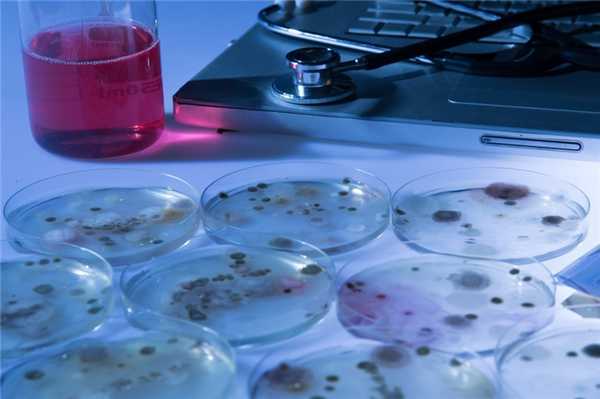
Споры: смертельно опасная форма возбудителя сибирской язвы

Сибирская язва. История изучения сибирской язвы
Добавил пользователь Валентин П. Обновлено: 01.11.2025
Сибирская язва (Anthrax) - инфекционная болезнь животных и человека, относящаяся к группе особо опасных инфекций. Сибирская язва характеризуется глобальным распространением. Заболевание встречается на всех континентах, свободны от него лишь часть северных регионов, Новая Зеландия и небольшие островные территории.
Сибирская язва известна с древности. Вспышки заболевания, похожего на сибирскую язву, были зафиксированы в древних китайских рукописях еще 5 тысяч лет назад. Описание эпидемии, поразившей Европу в I веке до нашей эры, есть у древнеримского поэта Вергилия - по его словам, болезнь "жилы сушила, потом несчастным корчила члены" и поражала "кости все до одной, постепенно язвимые хворью". Некоторые историки полагают, что это заболевание существовало и в Древнем Египте эпохи фараонов и могло стать пятой из десяти казней египетских, описанной в Библии такими словами: "то вот, рука Господня будет на скоте твоем, который в поле, на конях, на ослах, на верблюдах, на волах и овцах: будет моровая язва весьма тяжкая".
В нашей стране в прошлом она проявлялась в виде массивных эпизоотий, сопровождавшихся высоким уровнем поражения и смертности людей. Заполярная территория Западной Сибири до середины ХХ века была крайне неблагополучной по сибирской язве. Опустошительные эпизоотии этой инфекции среди северных оленей здесь становились обычным явлением. Современное название болезни на русском языке ей дал в конце XVIII века русский врач Степан Андреевский. Бактерия Bacillus anthracis впервые была выделена в 1876 г. немецким микробиологом Робертом Кохом. В 1881 г. французский микробиолог и химик Луи Пастер создал прививку против сибирской язвы для животных. Впервые вакцина для человека была создана в 1940 г. сотрудниками Санитарно-технического института Красной армии (г. Киров).
В настоящее время к наиболее опасным в плане заражения странам относятся Бангладеш, ряд стран Западной, Центральной и Южной Африки, а также Турция. Россия относится к категории стран со спорадической (редкие, единичные случаи) заболеваемостью, болезнь приобретает характер «возвращающейся инфекции». На граничащих с Россией территориях Грузии, Казахстана, Монголии и Китая также периодически выявляются случаи сибирской язвы.
Возбудитель сибирской язвы - Bacillus anthracis. Основные хозяева возбудителя сибирской язвы - травоядные животные, как сельскохозяйственные, так и дикие.
Особенности возбудителя, а именно способность существовать в природе в трех формах - вегетативной, капсульной и споровой, обусловили его способность длительное время выживать во внешней среде, прежде всего в почве, приспосабливаясь к неблагоприятным условиям.
Спорообразование происходит вне живого организма. Споры способны неопределенно долго пребывать в почве, служащей резервуаром инфекции, с образованием стойких почвенных очагов сибирской язвы. В прошлые века трупы животных, павших от сибирской язвы, закапывались в землю, что приводило к формированию почвенных очагов сибирской язвы, в которых споры возбудителя могут сохраняться в течение многих десятилетий. При определенных условиях, таких как размывание верхних слоев почвы в результате обильных осадков или проведение работ, связанных с выемкой и перемещением грунта, споры возбудителя могут выноситься на поверхность и распространяться по территории. Это может приводить к заражению сельскохозяйственных животных при выпасе и возникновению риска заражения людей. В настоящее время захоронение трупов животных, павших от сибирской язвы, строго запрещено.
Наиболее восприимчивы к сибирской язве мелкий рогатый скот (МРС - козы, овцы), крупный рогатый скот (КРС - коровы, буйволы, быки), лошади, ослы, верблюды и олени. У этих видов животных сибиреязвенная инфекция протекает обычно остро и, как правило, заканчивается смертельным сепсисом. Более устойчивы к сибиреязвенной инфекции свиньи, у них наблюдается хроническая форма болезни в виде сибиреязвенного шейного лимфаденита.
Возбудитель способен передаваться человеку различными механизмами - контактным, аспирационным, фекально-оральным и трансмиссивным. При этом ведущим механизмом передачи возбудителя, обеспечивающим поддержание эпидемического процесса, является контактный, реализующийся прямо или опосредованно. Люди заражаются сибирской язвой преимущественно в результате контакта с больными животными, их трупами или продуктами животноводства (при разделке и вынужденном убое больных животных); больной человек не заразен для окружающих.
Учитывая этот факт, а также первичную локализацию возбудителя в организме человека, сибирскую язву относят к группе инфекций наружных покровов.
В России принята концепция стационарно неблагополучных по сибирской язве пунктов (СНП), предложенная Б.Л. Черкасским (1999). Под ними понимаются территории, где когда-либо регистрировались заболевания людей или животных сибирской язвой. Расположение СНП необходимо учитывать при освоении новых земель, при осуществлении строительных, мелиоративных и прочих земельных работах, при промышленных разработках нефтяных и газовых месторождений и т. п. Места захоронения павших от сибирской язвы животных (почвенные очаги) представляют собой сохраняющуюся угрозу, несущую риск возникновения случаев заболевания животных и людей.
Основные причины периодически возникающих эпидемиологических осложнений по сибирской язве: неполный учёт сельскохозяйственных животных в личных хозяйствах, вынужденный убой больных животных без ветеринарного освидетельствования, несанкционированная реализация с/х продукции, употребление в пищу продуктов животного происхождения без достаточной термической обработки. В России на постоянной основе осуществляется надзор за СНП и почвенными очагами с целью недопущения эпидемических осложнений по сибирской язве. Основным направлением предупреждения заражения людей является вакцинация животных (вакцинация людей осуществляется по эпидпоказаниям).
В 2020 г. в Российской Федерации вспышка сибирской язвы с регистрацией заболевания одной головы крупного рогатого скота и пяти случаев инфицирования среди людей зафиксирована в Республике Дагестан. В течение последних трех лет в Республике Дагестан, в отличие от других регионов России, продолжает устойчиво проявляться эпизоотолого-эпидемиологическое неблагополучие по сибирской язве. В течение 2020 г. эпизоотолого-эпидемиологическое неблагополучие по сибирской язве отмечалось в пяти странах ближнего зарубежья - Кыргызстане, Казахстане, Грузии, Украине, Азербайджане. В дальнем зарубежье вспышки сибиреязвенной инфекции в 2020 г. среди людей имели место в странах Африки (Зимбабве, Кения, Уганда), Азии (Индонезия, Китай, Турция), Европы (Италия).
Таким образом, нынешняя ситуация по сибирской язве в мире и в России нестабильна, несмотря на выраженное снижение заболеваемости людей за последние три десятилетия, достигнутое прежде всего благодаря вакцинации сельскохозяйственных животных. Система эпиднадзора за сибирской язвой уже сейчас предусматривает мониторинг возбудителя, который должен и далее совершенствоваться, включать в себя новые методы молекулярного типирования, с созданием пополняемой электронной базы о геномах штаммов возбудителя сибирской язвы*.
*Подготовлено на основе материалов ФКУЗ РосНИПЧИ «Микроб» Роспотребнадзора
Управление Роспотребнадзора по Республике Марий Эл
Из истории эпидемиологии: Сибирская язва - RSS
Из истории эпидемиологии: Сибирская язва
*Подготовлено на основе материалов ФКУЗ РосНИПЧИ «Микроб» Роспотребнадзора
(По материалам с официального сайта Федеральной службы по надзору в сфере защиты прав потребителей и благополучия человека)
Возбудитель сибирской язвы - опасность, которая умеет ждать

Пять лет назад на Ямале произошло настоящее ЧП: погибло множество оленей и подросток. Больше трех десятков человек оказались инфицированы опасной болезнью — сибирской язвой. Предыдущая серьезная вспышка болезни в Ямало-Ненецком автономном округе произошла 80 лет назад, его уже давно считали свободным от этого заболевания. MedAboutMe разобрался, откуда появилась инфекция, почему ученые говорят о чрезвычайной ситуации и может ли эта вспышка угрожать остальным жителям Российской Федерации. Также попробуем ответить на вопросы: какие формы возбудителя сибирской язвы являются опасными для человека и как избежать инфицирования опаснейшим заболеванием.
История сибирской язвы

С этим заболеванием человечество знакомо уже много лет. Еще в древнеегипетских хрониках есть упоминания о похожей болезни. О сибирской язве писали арабские алхимики, прославленные греки и образованные римляне. Такое заболевание называли «священным» или «персидским огнем». Одна из теорий гласит, что сибирская язва распространялась по всей планете вслед за травоядными животными. Исторические хроники сохранили данные о нескольких крупных эпидемиях и эпизоотиях, которые происходили на территории Европы с начала ІX века. Вспышки «коровьей смерти» или «пупыруха» (народное название сибирской язвы) происходили и в разных частях России. Распространенность заболевания в Сибири привела к тому, что доктор С.С. Андреевский дал ему соответствующее название в своей работе «О сибирской язве». Путем самозаражения ему же удалось доказать, что люди и животные страдают от одной и той же болезни, а не от разных.
В середине ХІХ века сразу нескольким ученым удалось описать возбудителя сибирской язвы. А известный микробиолог Роберт Кох в 1876 г. успешно получил его в чистой культуре. В течение нескольких следующих лет ученые активно изучали сибирскую язву, и им удалось:
- разработать реакцию преципитации, которая позволяла выявлять возбудителя (Асколи, 1877);
- создать первую вакцину для специфической иммунопрофилактики сибирской язвы (Луи Пастер, 1881);
- разработать еще одну вакцину в России (Л.С. Ценковский, 1882).
По мере развития науки ученые научились создавать вакцины на основе штаммов-продуцентов сходных бактерий, которые можно получить при помощи методик генной инженерии. На сегодняшний день используются лишь безопасные и эффективные вакцины.
Относительно недавно сибирская язва уносила жизни 16 тысяч людей в год. Сейчас, как показывают данные Роспотребнадзора, в России ежегодно фиксируется не более 15-50 случаев такого заболевания. Причем чаще всего его выявляют у людей, которые непосредственно контактируют с животными.
Споры: смертельно опасная форма возбудителя сибирской язвы
Сибирская язва относится к заболеваниям-зоонозам. Другими словами, она поражает животных, но может развиться и у человека. Сибиреязвенная инфекция может представлять опасность для любого рогатого скота (и диких, и домашних особей). В случае вспышки на Ямале ее жертвой стали олени.
Возбудитель сибирской язвы — это неподвижная палочковидная бактерия, известная как Bacillus anthracis. По своей форме она напоминает бамбуковую тросточку. Вегетативная форма бактерии находится в состоянии роста и размножения, является жизнеспособной и жизнедеятельной. Она довольно уязвима и легко гибнет при повышенной температуре и применении самых распространенных дезинфицирующих средств. Но Bacillus anthracis умеют образовывать споры — так называемые покоящиеся формы возбудителя сибирской язвы. Они являются жизнеспособными, но не жизнедеятельными и проявляют поразительную устойчивость к температуре, дефициту влажности и другим факторам. Споры сложно даже сжечь, ведь при воздействии сухого жара с температурой 140 °С они сохраняют жизнеспособность в течение 3 часов. Споры сибирской язвы могут оставаться в покое на протяжении многих сотен лет до попадания в организм жертвы. После этого бактерии начинают активно размножаться, продуцируя сибиреязвенный токсин, который в свою очередь приводит к гибели организма.
Bacillus anthracis — это уникальная бактерия. Споры являются обязательным этапом цикла ее развития. После того как бациллы попадают в организм, они постепенно убивают своего носителя. К моменту гибели бактерии находятся во всех биологических жидкостях организма. Когда труп разлагается на открытом воздухе (с температурой 12-42 °С), происходит постепенное образование спор. Останки инфицированных животных привлекают грызунов и разных хищников, которые быстро распространяют болезнь по окружающей территории. И даже после разложения трупа споры находятся в грунте и могут привести к инфицированию травоядных животных, пришедших кормиться на это место.
Именно споры сыграли роль тайного оружия, настоящей мины замедленного действия, рванувшей 5 лет назад в Ямало-Ненецком АО.
Как убивает сибирская язва?
У людей и животных такое заболевание развивается по-разному. Инфицирование человека может привести к развитию трех разных форм болезни:
Такое заболевание возникает, если человек вдыхает споры, и оно считается самой тяжелой формой сибирской язвы. Болезнь развивается за считанные часы, ведь после проникновения в легочные альвеолы споры быстро прорастают и достигают лимфатических узлов. Температура тела больного вырастает до 40 °С, возникают кашель, насморк и конъюнктивит (как при тяжелом гриппе). Самочувствие ухудшается с каждым часом, появляются боли в груди, сильно снижается артериальное давление, развивается тахикардия, а в откашливаемой мокроте появляются прожилки крови. При отсутствии лечения гибель наступает в течение пары дней.
Такая форма болезни развивается в 95% случаев, когда споры проникают в организм сквозь кожные повреждения (порезы, укусы, ссадины и пр.). Споры быстро прорастают, но их распространение задерживают лимфоузлы. В месте проникновения инфекции спустя пару дней формируется зудящий узелок (папула), которая вскоре становится пустулой, а затем — крупным гнойником (карбункулом). Такое образование со временем лопается, оставляя после себя струп с черной верхушкой. Именно этим симптомом обусловлено европейское название болезни — антракс (anthrax — уголь). В течение суток температура вырастает до 40 °С, больного беспокоят слабость, частое сердцебиение, головная боль. Спустя 5-7 суток язвы заживают, затем на их месте формируются рубцы.
До открытия антибиотиков кожная форма сибирской язвы приводила к гибели 20% больных. Сейчас летальность составляет 1%.
В том случае, если споры проникли в организм сквозь пищеварительный тракт (например, при приеме в пищу непрожаренного мяса зараженного животного или его крови), они начинают прорастать в тонкой кишке. Такая форма болезни проявляется диареей, режущими болями в кишечнике, повышением температуры и появлением крови в рвотных массах. Отсутствие адекватного лечения приводит к гибели больного.
Вне зависимости от формы заболевания, сибирская язва может осложниться сибиреязвенным сепсисом — заражением крови. Проникновение инфекции в ткани других органов приводит к возникновению соответствующих болезней вторичного характера: поражению печени, почек, селезенки, тканей головного мозга и пр.
Кожная разновидность сибирской язвы считается самой слабой формой болезни.
Основной опасностью сибирской язвы, которая отличает ее от прочих инфекционных заболеваний, является стремительность развития патологического процесса. Также болезнь характеризуется высокой летальностью. Поэтому спецслужбы разных государств неоднократно использовали ее в качестве биологического оружия:
Ученые предполагают, что возможная вспышка сибирской язвы в Екатеринбурге (тогда — Свердловске), которая произошла в апреле 1979 г., вызвана аварийным выбросом препарата, над которым работали сотрудники военного НИИ.
Нашумевшая история в 2001 г. в Америке о письмах со смертельными спорами связана именно с легочной формой сибирской язвы. Также эту инфекцию пытались использовать при неудавшемся теракте в Японии в 1993, организованном членами секты «Аум Синрикё».
Можно ли защититься от сибирской язвы?

Инфицирование сибирской язвой происходит не от живых бактерий, а от спор. Поэтому больные животные и люди не несут угрозы для здорового человека. Споры формируются лишь у трупов — при контакте бактерий с кислородом, поэтому опасность несут тела и места их захоронения.
Пути заражения сибирской язвой человека включают:
- прием в пищу сырого мяса и/или крови погибшего от болезни животного;
- непосредственный контакт со шкурой погибшего инфицированного животного.
Риск инфицирования особенно высок у кочевых народов, так как они традиционно употребляют сырое мясо и кровь. Обычные люди могут столкнуться с болезнью при приобретении шкуры или мяса, не прошедших ветеринарный контроль.
К счастью, сибирская язва отлично поддается терапии даже обыкновенным пенициллином, поэтому для успешного лечения нужно лишь вовремя поставить правильный диагноз. Своевременное лечение дает неплохие шансы на выживание. Однако, как показывают данные статистики, даже люди из группы риска нередко не обращают внимания на первые проявления болезни, списывая их на обыкновенную простуду или расстройство желудка. Поэтому заболевание может распространяться. Но смертельные случаи, к счастью, встречаются редко.
При малейшем подозрении на развитие болезни врачи используют антибактериальные препараты.
Вакцинация позволяет достичь сформированного иммунитета уже спустя неделю. Чтобы защита оставалась на должном уровне, необходимо повторять прививку раз в 2 года. Но вакцинация показана не всем. В первую очередь такую процедуру проводят людям из группы риска:
- геологам, работающим в тундре;
- работникам лабораторий, изучающих сибирскую язву;
- лицам, которые регулярно контактируют с мясом и прочими продуктами животного происхождения;
- местным жителям, которые обитают в окрестностях очага заражения.
В печально известном Ямало-Ненецком округе вакцинацию от сибирской язвы отменили в 2007 г.
Скотомогильник — мина замедленного действия
Распространение сибирской язвы тесно связано с понятием скотомогильников. Это специальные места, в которых проводится захоронение животных, погибших от эпизоотии (массовой инфекции). Скотомогильники особей, павших от сибирской язвы, создавались по всей России в течение многих лет. А история составления их полной карты остается туманной и полной белых пятен.
Как показывают данные официальной статистики, на 2013 г. на территории РФ насчитывается 3871 скотомогильник (при этом в Московской области — 119). Треть участков из этого списка являются безхозными — их состояние никто не контролирует. Кроме того, по всей стране есть множество неучтенных захоронений, ведь до 1940-х годов ямы-захоронения организовывали у каждого села. Поэтому ученые предполагают, что количество сибиреязвенных захоронений в России достигает 35 тысяч.
В современном мире для утилизации трупов павших животных используют абсолютно другие технологии. В частности, вместо захоронений принято создавать «чешские ямы» - биотермические захоронения. Для их организации ямы выкладывают кирпичом и закрывают саркофагом из бетона или глины. Перед консервацией ямы трупы обязательно засыпают негашеной известью. Место захоронения также обносят забором с колючей проволокой, вокруг вырывают ров и устанавливают предупреждающие таблички: «Опасно, сибирская язва!». Также для устранения сибиреязвенных останков могут использоваться специальные печи (обыкновенный костер не уничтожает споры болезни).
В СССР при животноводческих хозяйствах строили скотомогильники с «чешскими ямами». Однако сейчас на это никто не выделяет финансов, поэтому фермеры просто сжигают павших животных, поливая их бензином, или оборудуют нелегальный скотомогильник.
Лариса Севрюгина, представитель Россельхознадзора по Тюменской области, ЯНАО и ХМАО, заявляет, что последнее обновление карт сибиреязвенных захоронений и журналов учета эпизоотических очагов было еще в 1914 г. В соответствии с этим данными на территории региона находится 2 скотомогильника и 47 «падежных мест». Глубина таких захоронений составляет всего несколько метров. И таких скотомогильников много в разных регионах России. Это — мины, способные взорваться в любой момент.
Вспышка сибирской язвы на Ямале в 2016 г.

Наиболее масштабный падеж оленей в ЯНАО был зафиксирован в 1911 г. - тогда погибло более 100 тысяч особей. Последняя крупная вспышка болезни в этом регионе произошла в 1941 г., а с 1968 г. Ямал официально признали свободным от данной инфекции. Подобное признание говорит о том, что в многочисленных пробах грунта и воды споры сибирской язвы не были обнаружены, а случаи заболевания не фиксировались в течение длительного времени. До 2016 года.
Источником инфекции стал расконсервировавшийся скотомогильник. Ученые пришли к выводу, что его расконсервация была спровоцирована необычайно теплой погодой, когда больше месяца в регионе держалась жара в 35 °С.
В ликвидации последствий вспышки принимали участие сотрудники Министерства обороны РФ и Министерства чрезвычайных ситуаций. Сейчас все поголовье оленей на Ямале подвергается маркировке и вакцинации от сибирской язвы. С оленеводами ведется активная разъяснительная работа с привлечением депутатов и старейшин.
Как не заразиться сибирской язвой?
Теоретически, инфекция может распространяться за пределы зараженной территории вместе с грунтовой пылью и водой. Однако ученые уверены, что риски инфицирования в этом отношении минимальны. Поэтому тем, кто находится в зоне карантина, стоит использовать бутилированную воду и воду из подземных источников. Также необходимо отказаться от сбора ягод и грибов.
Наиболее реальный путь инфицирования — через зараженное мясо, кровь и шкуры погибших от сибирской язвы животных. Поэтому, чтобы защитить себя от болезни, необходимо:
Неукротимая инфекция: сибирская язва

Сибирская язва получила свое название благодаря русскому врачу С. Андреевскому, который в 1788 году дал описание крупной вспышки в западносибирских районах страны. Инфекция эта очень серьезная, поэтому важно на первых порах перехватить ее развитие с помощью антибиотиков (а для профилактики используется вакцина). О симптомах заболевания читайте в нашей статье.
Сибирская язва: исторический экскурс

О сибирской язве сообщают манускрипты Древнего Египта и Ближнего Востока: в документах древности заболевание именуется как «персидский огонь» или «священный огонь». Упоминание о ней есть и в Книге Бытия, где рассказывается о Пятой и Шестой казнях. Так, Пятая принесла египетскому народу падеж скота, а шестая поразила нарывами и язвами самих египтян.
Римский писатель Вергилий в своей поэме «Георгики» пишет о скотоводстве и повествует о болезнях лошадей, коров, овец и диких животных, а среди признаков указывает кровь и характерные пятна, по цвету напоминающие сажу. Поэтому сибирская язва в западной медицине, а точнее ее возбудитель получил наименование Bacillus anthracis, поскольку на греческом языке это означало «уголь» (теперь это международное название).
В России укоренилась традиция закапывать в землю трупы зараженных животных, и такие места огораживали. Позднее в СССР стали систематизировать и наносить на военные карты такие могильники.
В XIX веке ученые сумели идентифицировать крохотные палочки в крови заболевших овец и предположили, что эти частицы вызывают сибирскую язву, но объяснить, каким образом ими заражаются − не смогли.
Немецкий исследователь Роберт Кох взялся за изучение причин сибирской язвы: он проводил эксперименты на мышах, заражая кровью инфицированных коров, и тем самым подтвердил догадки, что бациллы передаются через кровь. Кроме того, он заметил, что в неподходящих для размножения условиях, в частности при недостатке кислорода, бациллы сибирской язвы включают своего рода защитный механизм в виде формирования округлых спор, которые будто бы впадают в спячку и выжидают. А когда появляются нормальные условия, из спор развиваются бациллы, поэтому вспышка инфекции может начаться без прямых контактов с больными животными.
Не так давно в Ямало-Ненецком округе случилась эпидемия. Как выяснилось, на месте выпаса скота были старые скотомогильники. А в 2016 году в результате аномального теплого лета земля подтаяла, споры Bacillus anthracis активизировались, и сибирская язва спустя многие годы снова напомнила о себе.
Симптомы сибирской язвы
Бациллы сибирской язвы весьма неприхотливы, что обусловило их невероятно высокую живучесть, особенно спорам − им не страшны сильный холод и высокие температуры. Когда споры оказываются на слизистой дыхательных путей и желудочно-кишечном тракте, они прорастают, на их месте проклевываются бактерии Bacillus anthracis. Те, в свою очередь технично упаковываются в созданную ими же капсулу, которая идентична клеткам иммунной системы, отчего макрофаги, призванные распознавать и поглощать чужеродные элементы, не видят вражеский десант. Последний внедряется в лимфоузлы, размножается и начинает выделять токсины (самое опасное в заражении). От этого и появляются характерные симптомы: карбункулы, отеки и некрозы тканей, геморрагическое воспаление. Активность бактерий провоцирует отказ почек, нарушает свертываемость крови и кислотно-щелочной баланс. Все вместе это ведет к гибели зараженного, будь то человек или животное.
Источником инфекции традиционно становятся травоядные. Поглощая зараженную спорами траву или воду, они выделяют возбудителя через отходы жизнедеятельности. Люди заражаются преимущественно контактным путем через микротравмы в слизистых оболочках и кожных покровах, например, при разделке туш. А между людьми инфекция не передается.
Инкубационный период может составить несколько часов или несколько дней, до двух недель. Симптомы зависят от формы заболевания: кожной и генерализованной.
При кожной форме, или сибиреязвенном карбункуле, на поверхности тела появляется красно-синеватое пятно, на его месте образуется зудящая папула, в центре которой спустя сутки возникает пузырек с серозной жидкостью. Он быстро темнеет и приобретает кровянистый вид, а когда лопается, то появляется темная язва. В течение нескольких дней язва видозменяется, становясь плотным черным струпом, похожим на уголек. За счет того, что возле струпа формируются мелкие пузырьки, переходящие в мелкие язвы, первоначальный струп растет в размерах, а ткани вокруг него отекают. Характерно, что все это происходит практически безболезненно.
У генерализованной формы есть три типа.
- Симптомы при легочном типе походят на классическую простуду: температура, кашель, насморк, тахикардия. Затем приметы интоксикации нарастают, температура поднимается до высоких пределов, при кашле отходит кровянистая слизь. Последняя стадия обозначается сердечно-сосудистой недостаточностью, олигурией, отеком легких.
- Кишечный тип может развиваться при поедании зараженных продуктов, отличается тяжелым течением и высокой летальностью. В первые сутки возникают головная боль, дискомфорт в горле, головокружение, температура. Затем появляются тошнота, острые боли в животе, рвота с кровью, жидкий стул с кровянистыми выделениями. Для последней стадии характерная сердечная недостаточность, лицо приобретает розовато-синюшный цвет, а на коже нередко выступают папулезные или геморрагические сыпи.
- Септический тип чаще всего становится вторичным этапом предыдущих форм инфекции. При нем интоксикация стремительно нарастает, отмечается множество кровоизлияний, и часто наблюдается инфекционно-токсический шок.
Вакцина от сибирской язвы

Большинство эпизодов сибирской язвы легко разрешимы при своевременном использовании лекарственных средств (антибиотиков).
В эндемичных районах для лиц из группы риска предусмотрена профилактика в виде иммунизации. Вакцину ставят ветработникам, животноводам, сотрудникам лабораторий и людям, которые непосредственно контактируют со скотом, занимаются транспортировкой и переработкой животного сырья.
Подкожная вакцина используется при эпидемических ситуациях, а накожная — при плановых осмотрах.
«Священный огонь» Древнего мира: сибирская язва

Сибирская язва (Bacillus anthracis) знакома многим регионам планеты, и чаще всего она встречается в странах, где развито животноводство. Это острая инфекционная болезнь, которой подвержены животные и люди, и ее проявления всегда ярко выражены: сильная интоксикация, лихорадка, для кожной формы заболевания характерны образования карбункулов, а для легочной и кишечной — сепсис.
Сибирская язва: история открытия
О сибирской язве человечеству стало известно много столетий назад, о ней писали еще ученые мужи и врачеватели древности. В их трудах заболевание обретало множество названий: углевиком (anthrax) ее называл Гиппократ, «священным огнем» — Геродот, «персидским огнем» — лекари персидских стран. В более поздние эпохи сибирская язва именовалась сибиркой, злокачественным или сибиреязвенным карбункулом.
В 1766 г. французский врач С.Ф. Моран представил научному сообществу доклад, посвященный сибирской язве, и это был первый исследовательский труд с наиболее полным описанием инфекции.
Под современным названием инфекция стала известна в 1788 г., когда в Сибири разразилась крупная эпидемия, и русским врачом С. Андреевским в сочинении «О сибирской язве» представлено детальное изображение болезни. Кроме того, в рамках экспериментального подхода Андреевский провел опыт самозаражения, дабы доказать, что инфекция может передаваться от животных человеку. Именно после Андреевского болезнь стала именоваться сибирской язвой.
О кожной форме болезни упоминал еще в 1762 г. отечественный ученый Н. Кожевников. О кишечной форме впервые написал русский исследователь Р.С. Чатыркин, отметивший взаимосвязь заболевания с употреблением мяса зараженного животного.
В 1849 году ученый F.Pollender, исследуя мазки крови мертвых животных, которых погубила сибиреязвенная болезнь, разглядел в них возбудителя инфекции. Но только в 1863 г. французский биолог K.Davaine доказал, что присутствующие в крови крупные палочки с обрубленными концами и есть чужеродный агент смертоносного действия.
В 1863 г. немецкий ученый Роберт Кох делает открытие — путем экспериментов ему удалось выделить чистую культуру возбудителя и отследить процесс образования споров, которые могут длительное время бытовать во внешней среде.
Вакцинопрофилактика сибирской язвы берет свое начало с 1861 г., когда французский микробиолог Луи Пастер разработал прививку от этой инфекции для животных. Созданное им лекарство легло в основу снижения заболеваемости сибирской язвой не только среди животных, но также среди людей.
Инфекция сибирской язвы: этиология

Сибирская язва — зоонозная инфекция, резервуаром которой выступают животные (овцы, верблюды и крупный рогатый скот). В основном она протекает в кожной форме, тогда как другие две — кишечная и легочная — встречаются реже. Бацилла Bacillus anthracis способна к спорообразованиям, которые хорошо приспосабливаются во внешней среде, в частности — активно произрастают в почве, где живут более десяти лет.
Инфицирование людей происходит на основе контактирования не только непосредственно с заболевшими животными, но также и при соприкосновении со шкурой, мясом и кровью инфицированного животного. Кроме того, и почва, где находятся споры возбудителя сибирской язвы, является заразной.
- Вратами инфекции при кожной форме становятся различные микротравмы кожного покрова. После того, как возбудитель сибиреязвенной болезни внедрится в кожу, следует его активное размножение, в ходе которого выделяется экзотоксин, из-за чего наступает некроз тканей и отек.
- Кишечная форма болезни возникает после поедания зараженной пищи (алиментарное инфицирование), в связи с чем споры сибирской язвы оказываются в подслизистой оболочке, а также регионарных лимфоузлах.
- Легочная форма вызывается аэрогенным способом попадания зараженных частичек воздуха в легкие, отчего начинается сибиреязвенная пневмония вторичного геморрагического типа.
Поскольку возбудители инфекции по лимфатическим сосудам проникают в кровь и тем самым поражают органы и системы организма, то, помимо очаговой, возможна генерализованная форма болезни.
В тропических странах инфицирование случается и от укуса кровососущих насекомых.
Симптомы язвы у человека

Симптомы язвы дифференцируются в зависимости от формы заболевания, которое развивается после инкубационного период длительностью не более восьми дней.
- Кожная форма выражена разновидностями: эризипелоидная, эдематозная, буллезная и карбункулезная.
Более всего имеет место быть последняя клиническая разновидность кожного проявления сибиреязвенной инфекции — карбункулезная. Сначала появляется красное пятно с небольшим возвышением над уровнем кожи, затем в схематичной последовательности на этом же месте образуются папула, везикула, пустула и, наконец, формируется язва. Весь процесс преобразования пятна в язву занимает несколько часов. Больные чувствуют в месте инфекционного очага жжение и зуд, что провоцирует расчесывание сыпи и образование язвы с коркой в районе поврежденных пустул. Центральный струп язвы окружен мелкой сыпью (вторичные пустулы), кроме того, в области язвы кожа гиперемирована, имеет отечный вид и практически полностью утрачивает чувствительность. Локализация язвенных проявлений чаще всего отмечается на верхних конечностях, затем на лице, груди, спине, и в редких случаях на нижних конечностях.
Температура тела в первые сутки болезни достигает 40°C, больные чувствуют сильную слабость, головную боль, тахикардию вкупе с резким упадком сил. Такое состояние длится в течение недели, затем температура резко падает, а струп язвы на второй или третьей недели отторгается при заметном заживлении карбункула.
При эдематозной разновидности появляется отек без карбункула, который сменяется некрозом тканей со струпом. Буллезный вариант кожной формы имеет вид больших пузырей на воспаленном участке кожи, наполненных геморрагической жидкостью. Эризипелоидная разновидность характеризуется образованием белесых пузырьков с прозрачной жидкостью. Кожа также красная и припухшая.
Для всех трех форм симптомы язвы имеют схожую основу — всегда наблюдается лихорадка с высокой температурой.
Читайте также:
- Интерстициальные заболевания легких. Эозинофильная пневмония. Васкулиты. Эозинофильные плевриты.
- Диагностика краниофарингиомы по КТ, МРТ головного мозга
- Ладонно-подошвенная форма акральной лентигинозной меланомы
- Пульс у спортсменов перед стартом. Предстартовые систолические шумы сердца спортсменов
- Общие сведения о питании
